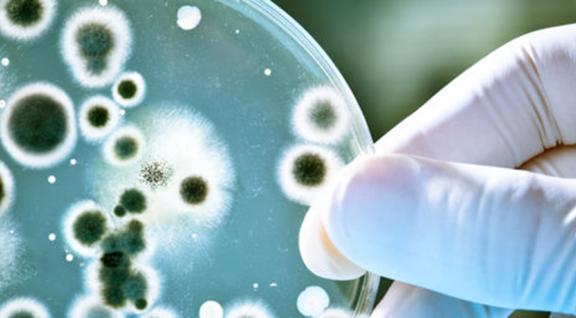

Rapport "Duurzaam en gezond, samen naar een houdbaar systeem"
De Raad voor de leefomgeving en infrastructuur (RLI) heeft in een advies van 3 april 2018 aan minister Schouten van Landbouw, Natuur en Voedselkwaliteit op een rij gezet wat het klima

De Raad voor de leefomgeving en infrastructuur (RLI) heeft in een advies van 3 april 2018 aan minister Schouten van Landbouw, Natuur en Voedselkwaliteit op een rij gezet wat het klima

Biogas is een zeer ontvlambaar gasmengsel dat bij inademing schadelijk kan zijn voor de gezondheid. Veilig gebruik van biogasinstallaties is dan ook van cruciaal belang.
Recente onderzoeken bevestigen eerdere bevindingen dat wonen in de buurt van veehouderijen effect kan hebben op de luchtwegen.


Fijnstof en gezondheid ging jaren vooral over de emissies door verkeer en industrie.


Onderzoekers van verschillende instituten ontdekten dat ESBL’s overal voorkomen binnen de veehouderij, het milieu en bij de mens zelf.
Het Vlaamse Instituut voor Landbouw, Visserij- en Voedingsonderzoek (ILVO) heeft in opdracht van de Provincie West-Vlaanderen het rapport “Intensieve veeteelt en de gezondheid van omwo

In Nederland blijkt dat mensen die in de buurt van geitenbedrijven wonen meer kans hebben op longontsteking dan mensen die verderop wonen.

Kennisbericht ter ondersteuning van GGD Bureau GMV in Noord-Brabant naar aanleiding van de publicatie van het aanvullend onderzoek VGO.
